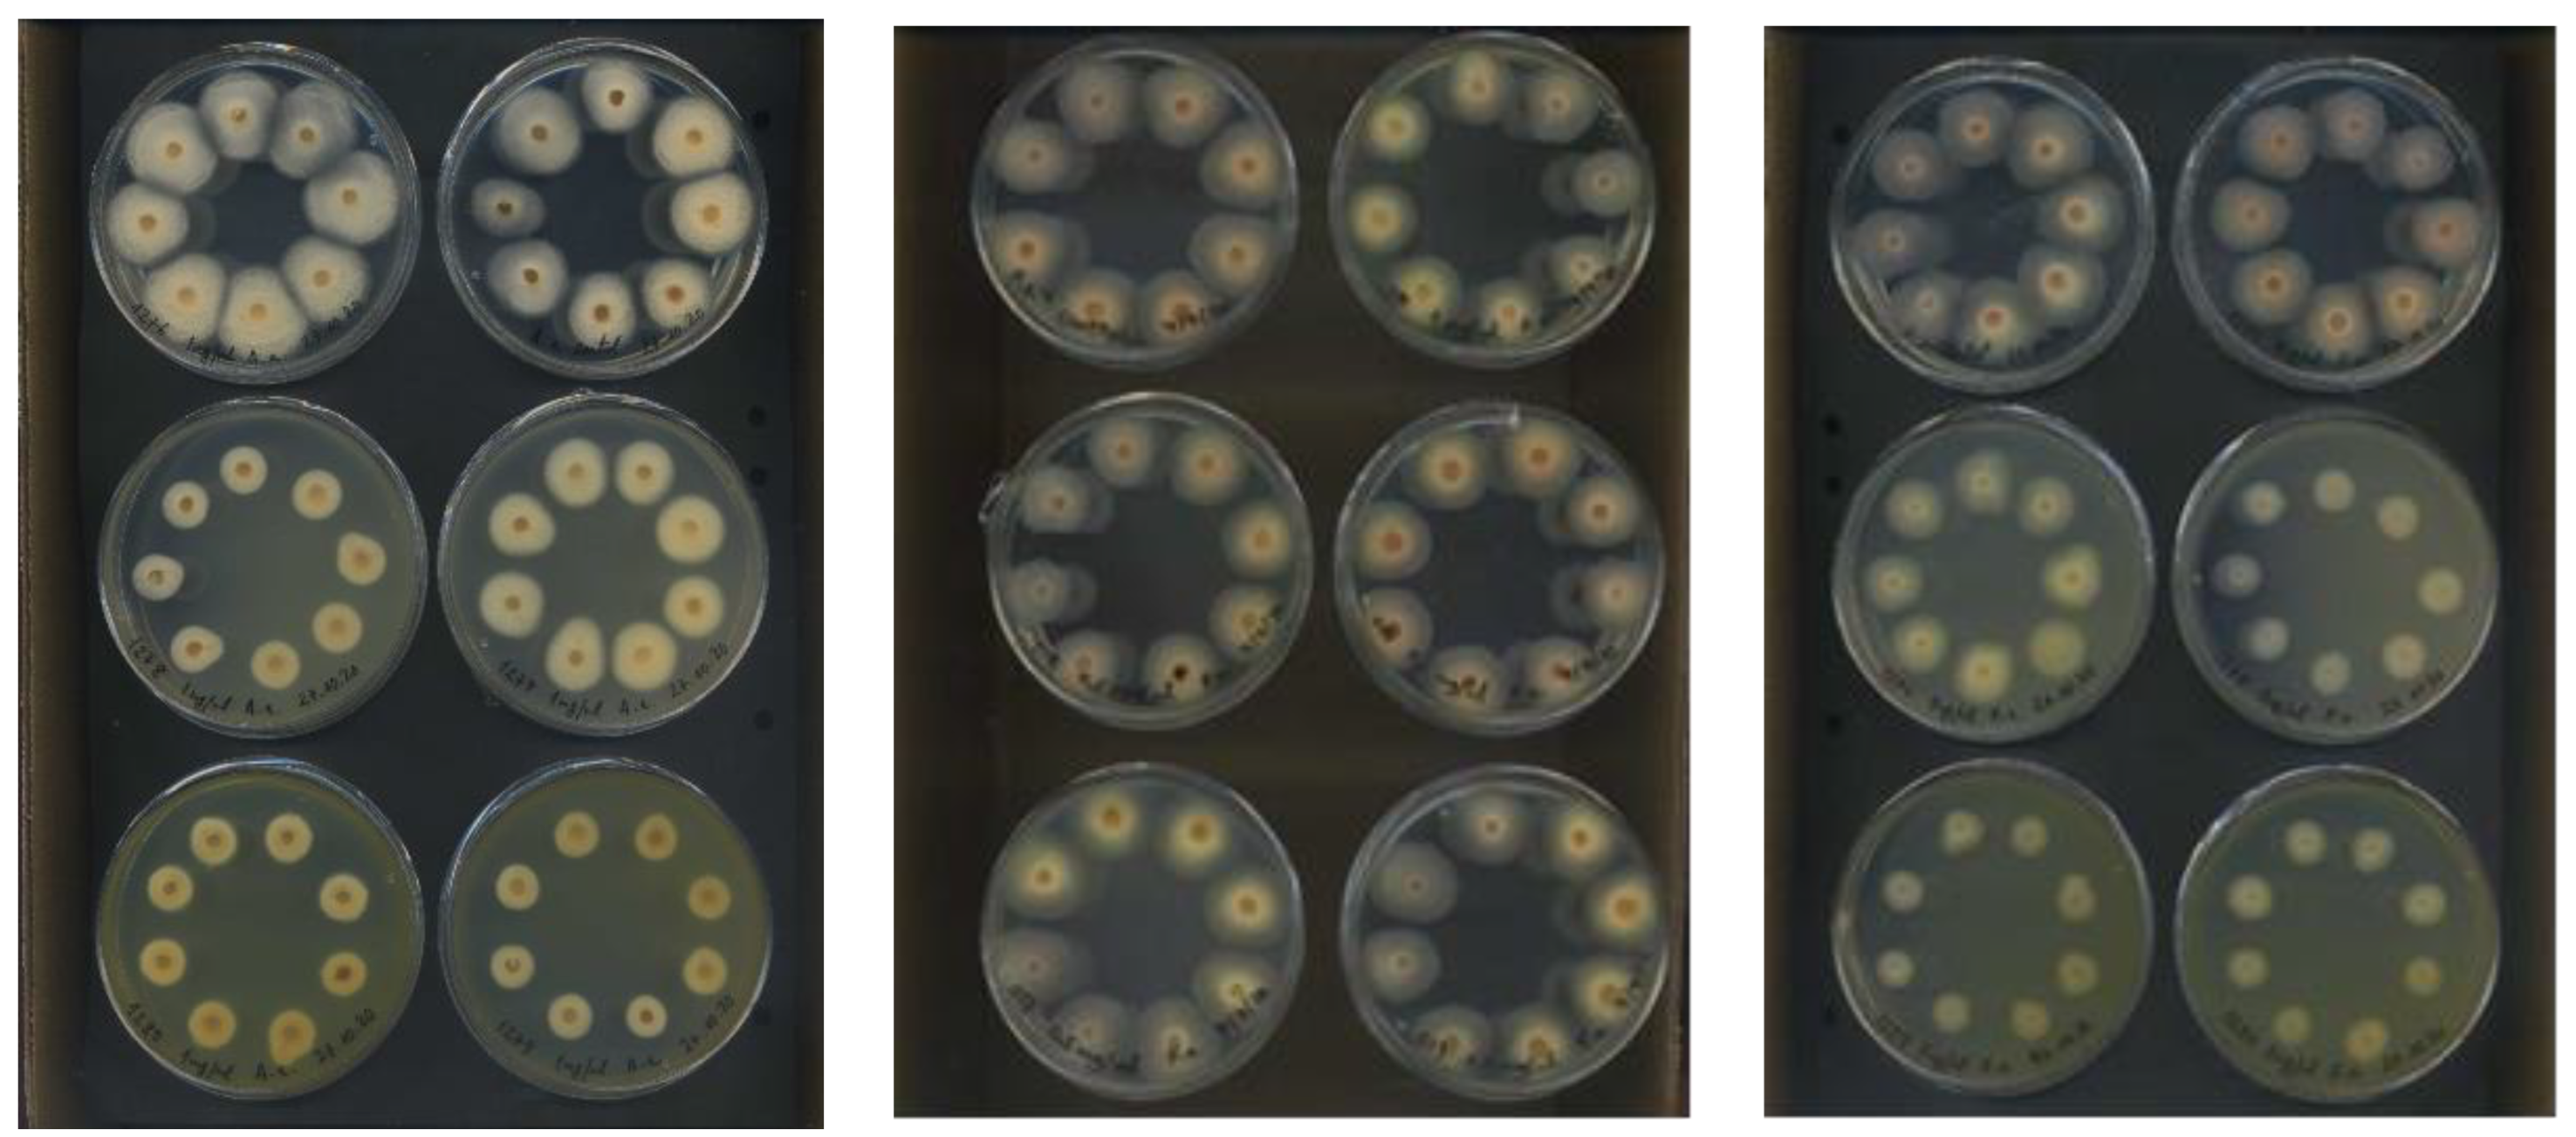
Applsci 13 06736 g004

Evaluation of Magonia pubescens A. St.-Hill. Roots Extract against Phytopathogens: Searching for Eco-Friendly Crop Protection Products
Abstract
1. Introduction
2. Materials and Methods
2.1. Chemicals and Reagents
2.2. Plant Material
2.3. Plant Extract Preparation
2.4. Liquid–Liquid Partition Procedure
2.5. In Vitro Test-Assay on Mycelium
2.6. Leaf-Disk Bioassay
2.7. Statistical Analysis
3. Results and Discussion
3.1. Antifungal In Vitro Test-Assay on Mycelium
3.2. Insect Antifeedant Activity against Chrysodeixis chalcites
4. Conclusions
Supplementary Materials
Author Contributions
Funding
Data Availability Statement
Acknowledgments
Conflicts of Interest
References
- 2050: A Third More Mouths to Feed. Available online: https://www.fao.org/news/story/en/item/35571/icode/ (accessed on 14 November 2022).
 - Handelman, H.; Brynen, R. Challenges of the Developing World, 9th ed.; Rowman & Littlefield Publishers, Pearson Education, Inc.: Lanham, Maryland, 2019. [Google Scholar]
 - Pandian, S.; Ramesh, M. Development of pesticide resistance in pests: A key challenge to the crop protection and environmental safety. In Pesticides in Crop Production: Physiological and Biochemical Action, 1st ed.; Srivastava, P.K., Singh, V.P., Singh, A., Tripathi, D.K., Singh, S., Prasad, S.M., Chauhan, D.K., Eds.; Willey: New Jersey, NJ, USA, 2020; pp. 1–13. [Google Scholar]
 - De Simone, N.; Pace, B.; Grieco, F.; Chimienti, M.; Tyibilika, V.; Santoro, V.; Capozzi, V.; Colelli, G.; Spano, G.; Russo, P. Botrytis cinerea and table grapes: A review of the main physical, chemical, and bio-based control treatments in post-harvest. Foods 2020, 9, 1138. [Google Scholar] [CrossRef] [PubMed]
 - Rocha, A.J.; Soares, J.M.S.; Nascimento, F.S.; Santos, A.S.; Amorim, V.B.O.; Ferreira, C.F.; Haddad, F.; Santos-Serejo, J.A.; Amorim, E.P. Improvements in the resistance of the banana species to Fusarium Wilt: A systematic review of methods and perspectives. J. Fungi 2021, 7, 249. [Google Scholar] [CrossRef] [PubMed]
 - Wenderoth, M.; Garganese, F.; Schmidt-Heydt, M.; Soukup, S.T.; Ippolito, A.; Sanzani, S.M.; Fischer, R. Alternariol as virulence and colonization factor of Alternaria alternata during plant infection. Mol. Microbiol. 2019, 112, 131–146. [Google Scholar] [CrossRef] [PubMed]
 - Azevedo, D.M.Q.; Martins, S.D.S.; Guterres, D.C.; Martins, M.D.; Araújo, L.; Guimaraes, L.M.S.; Alfenas, A.C.; Furtado, G.Q. Diversity, prevalence and phylogenetic positioning of Botrytis species in Brazil. Fungal Biol. 2020, 124, 940–957. [Google Scholar] [CrossRef]
 - Würz, D.A.; Rufato, L.; Bogo, A.; Allebrandt, R.; Bem, B.P.; Marcon-Filho, J.L.; Brighenti, A.F.; Bonin, B.F. Effects of leaf removal on grape cluster architecture and control of Botrytis bunch rot in Sauvignon Blanc grapevines in Southern Brazil. Crop Prot. 2020, 131, 105079. [Google Scholar] [CrossRef]
 - Maia, J.N.; Beger, G.; Pereira, W.V.; De Mio, L.L.M.; Duarte, H.S.S. Gray mold in strawberries in the Paraná state of Brazil is caused by Botrytis cinerea and its isolates exhibit multiple-fungicide resistance. Crop Prot. 2021, 140, 105415. [Google Scholar] [CrossRef]
 - Chitolina, G.M.; Silva-Junior, G.J.; Feichtenberger, E.; Pereira, R.G.; Amorim, L. First report on quinone outside inhibitor resistance of Alternaria alternata causing Alternaria brown spot in tangerines in São Paulo, Brazil. Plant Health Prog. 2019, 20, 94. [Google Scholar] [CrossRef]
 - FAOSTAT. Available online: https://www.fao.org/faostat/en/#rankings/countries_by_commodity (accessed on 14 November 2022).
 - Deltour, P.; França, S.C.; Heyman, L.; Pereira, O.L.; Höfte, M. Comparative analysis of pathogenic and nonpathogenic Fusarium oxysporum populations associated with banana on a farm in Minas Gerais, Brazil. Plant Pathol. 2018, 67, 707–718. [Google Scholar] [CrossRef]
 - Chitolina, G.M.; Silva-Junior, G.J.; Feichtenberger, E.; Pereira, R.G.; Amorin, L. Distribution of Alternaria alternata isolates with resistance to quinone outside inhibitor (QoI) fungicides in Brazilian orchards of tangerines and their hybrids. Crop Prot. 2021, 141, 105493. [Google Scholar] [CrossRef]
 - CABI. Chrysodeixis chalcites Datasheet; Database: Invasive Species Compendium [Internet]. 2022. Available online: https://www.cabi.org/isc/datasheet/13243 (accessed on 22 August 2022).
 - Çakmak, T.; Simón, O.; Kaydan, M.B.; Tange, D.A.; Rodríguez, A.M.G.; Díaz, A.P.-B.; Murillo, P.C.; Suárez, E.H. Effects of several UV-protective substances on the persistence of the insecticidal activity of the Alphabaculovirus of Chrysodeixis chalcites (ChchNPV-TF1) on banana (Musa acuminata, Musaceae, Colla) under laboratory and open field conditions. PLoS ONE 2021, 16, e0250217. [Google Scholar] [CrossRef]
 - Soares, J.R.S.; Da Silva, R.S.; Ramos, R.S.; Picanço, M.C. Distribution and invasion risk assessments of Chrysodeixis includens (Walker, [1858]) (Lepidoptera: Noctuidae) using CLIMEX. Int. J. Biometeorol. 2021, 65, 1137–1149. [Google Scholar] [CrossRef] [PubMed]
 - Gikas, G.D.; Parlakidis, P.; Mavropoulos, T.; Vryzas, Z. Particularities of fungicides and factors affecting their fate and removal efficacy: A review. Sustainability 2022, 14, 4056. [Google Scholar] [CrossRef]
 - Dey, D. Impact of indiscriminate use of insecticide on environmental pollution. Int. J. Plant Prot. 2016, 9, 264–267. [Google Scholar] [CrossRef]
 - Isman, M.B. Botanical insecticides in the twenty-first century–fulfilling their promise? Annu. Rev. Entomol. 2020, 65, 233–249. [Google Scholar] [CrossRef] [PubMed]
 - Acheuk, F.; Basiouni, S.; Shehata, A.A.; Dick, K.; Hajri, H.; Lasram, S.; Yilmaz, M.; Emekci, M.; Tsiamis, G.; Spona-Friedl, M.; et al. Status and prospects of botanical biopesticides in Europe and Mediterranean countries. Biomolecules 2022, 12, 311. [Google Scholar] [CrossRef] [PubMed]
 - Souto, A.L.; Sylvestre, M.; Tölke, E.D.; Tavares, J.F.; Barbosa-Filho, J.M.; Cebrián-Torrejón, G. Plant-derived pesticides as an alternative to pest management and sustainable agricultural production: Prospects, applications and challenges. Molecules 2021, 26, 4835. [Google Scholar] [CrossRef]
 - Rizvi, S.A.H.; Ikhlaq, M.N.; Jaffar, S.; Hussain, S. Efficacy of some selected synthetic chemical insecticides and bio-pesticides against cotton mealybug, Phenacoccus solenopsis Tinsley (Sternorrhyncha: Pseudococcidae) under agroecological conditions of Peshawar, Pakistan. J. Entomol. Zool. Stud. 2015, 3, 223–226. [Google Scholar]
 - Assadpour, E.; Can Karaça, A.; Fasamanesh, M.; Mahdavi, S.A.; Shariat-Alavi, M.; Feng, J.; Kharazmi, M.S.; Rehman, A.; Jafari, S.M. Application of essential oils as natural biopesticides; recent advances. Crit. Rev. Food Sci. Nutr. 2023, 63, 1–21. [Google Scholar] [CrossRef]
 - Tavares, W.R.; Barreto, M.C.; Seca, A.M.L. Aqueous and ethanolic plant extracts as bio-insecticides—Establishing a bridge between raw scientific data and practical reality. Plants 2021, 10, 920. [Google Scholar] [CrossRef]
 - Filho, J.G.S.; Almeida, A.S.; Pinto-Zevallos, D.; Barreto, I.C.; Cavalcanti, S.C.H.; Nunes, R.; Teodoro, A.V.; Xavier, H.S.; Filho, J.M.B.; Guan, L.; et al. From plant scent defense to biopesticide discovery: Evaluation of toxicity and acetylcholinesterase docking properties for Lamiaceae monoterpenes. Crop Prot. 2023, 164, 106126. [Google Scholar] [CrossRef]
 - Bellonzi, T.K.; Dutra, F.V.; Souza, C.N.; Rezende, A.A.; Gasparino, E.C. Pollen types of Sapindaceae from Brazilian forest fragments: Apertural variation. Acta Bot. Bras. 2020, 34, 327–341. [Google Scholar] [CrossRef]
 - Macedo, M.C.; Scalon, S.P.; Sari, A.P. Biometria de frutos e sementes e germinação de Magonia pubescens St.Hil (Sapindaceae). Rev. Bras. Sementes 2009, 31, 202–211. [Google Scholar] [CrossRef]
 - Rocha, J.D.; Carneiro, F.M.; Fernandes, A.S.; Morais, J.M.; Borges, L.L.; Chen-Chen, L.; de Almeida, L.M.; Bailão, E.F.L.C. Toxic potential of Cerrado plants on different organisms. Int. J. Mol. Sci. 2022, 23, 3413. [Google Scholar] [CrossRef] [PubMed]
 - Mesquita, M.L.; Paula, J.E.; Pessoa, C.; Moraes, M.O.; Costa-Lotufo, L.V.; Gourgnet, R.; Michel, S.; Tillequin, F.; Espindola, L. Cytoxic activity of Brazilian Cerrado plants used in traditional medicine against cancer cell lines. J. Ethnopharmacol. 2009, 123, 439–445. [Google Scholar] [CrossRef] [PubMed]
 - Arruda, W.; Oliveira, G.M.; Silva, I.G. Toxicidade do extrato etanólico de Magonia pubescens sobre larvas de Aedes aegypti. Rev. Soc. Bras. Med. Trop. 2003, 36, 17–25. [Google Scholar] [CrossRef]
 - Mendes, J.M. Ação Leishmanicida de Extratos de Plantas no Desenvolvimento de Promastigotas de Leishmania amazonensis e Estudo do Perfil Metabólico Utilizando a Técnica de Cromatografia Líquida de Alta Eficiência (CLAE). Master’s Thesis, Universidade Federal de Goiás, Goiania, Brazil, 2006. [Google Scholar]
 - Aguiar, M.M.; Santos, K.T.; Royo, V.A.; Fonseca, F.S.; Menezes, E.V.; Mercadante-Simões, M.O.; Oliveira, D.A.; Junior, A.F.J. Antioxidant activity, total flavonoids and volatile constituents of Magonia pubescens A. St.-Hil. Med. Plants Res. 2015, 9, 1089–1097. [Google Scholar]
 - Moraes, A.R.A.; Camargo, K.C.; Simões, M.O.M.; Ferraz, V.P.; Pereira, M.T.; Evangelista, F.C.G.; Sabino, A.P.; Duarte, L.P.; Alcântara, A.F.C.; Sousa, G.F. Chemical composition of Magonia pubescens essential oils and gamma-radiation effects on its constituents and cytotoxic activity in leukemia and breast cancer model. Chem. Biodivers. 2021, 18, e2100094. [Google Scholar] [CrossRef]
 - Filho, J.C.; Coelho, M.F.; Albuquerque, M.C.; Azevedo, R.A. Seedling emergence of Magonia pubescens St. Hil. Sapindaceae a function of temperature. Amaz. J. Agric. Environ. Sci. 2011, 54, 137–143. [Google Scholar]
 - Silva, L.B.; Silva, J.C.; Pavan, B.E.; Pereira, F.F.; Maggioni, K.; Andrade, L.H.; Candido, A.C.S.; Peres, M.T.L.P. Insecticide irritability of plant extracts against Sitophilus zeamais. Afr. J. Agric. Res. 2013, 8, 978–983. [Google Scholar]
 - Souza, M.J.; Mercadante-Simões, M.O.; Ribeiro, L.M. Secondary-cell-wall release: A particular pattern of secretion in the mucilaginous seed coat of Magonia pubescens. Am. J. Bot. 2020, 107, 31–44. [Google Scholar] [CrossRef]
 - Kupchan, S.M. Recent advances in the chemistry of terpenoid tumor inhibitors. Pure Appl. Chem. 1970, 21, 227–246. [Google Scholar] [CrossRef]
 - Cosoveanu, A.; Hernandez, M.; Iacomi-Vasilescu, B.; Zhang, X.; Shu, S.; Wang, M.; Cabrera, R. Fungi as endophytes in Chinese Artemisia spp.: Juxtaposed elements of phylogeny, diversity and bioactivity. Mycosphere 2016, 7, 102–117. [Google Scholar] [CrossRef]
 - Fosbel-Plus. Available online: https://www.infoagro.com/agrovademecum/fito_m.asp?nreg=22421 (accessed on 14 November 2022).
 - Liu, T.-X.; Zhang, Y. Side effects of two reduced-risk insecticides, indoxacarb and spinosad, on two species of Trichogramma (Hymenoptera: Trichogrammatidae) on cabbage. Ecotoxicology 2012, 21, 2254–2263. [Google Scholar] [CrossRef] [PubMed]
 - Bajonero, J.G.; Parra, J.R.P. Selection and suitability of an artificial diet for Tuta absoluta (Lepidoptera: Gelechiidae) based on physical and chemical characteristics. J. Insect Sci. 2017, 17, 13–20. [Google Scholar] [CrossRef] [PubMed]
 - Simón, O.; Bernal, A.; Williams, T.; Carnero, A.; Hernández-Suárez, E.; Muñoz, D.; Caballero, P. Efficacy of an alphabaculovirus-based biological insecticide for control of Chrysodeixis chalcites (Lepidoptera: Noctuidae) on tomato and banana crops. Pest Manag. Sci. 2015, 71, 1623–1630. [Google Scholar] [CrossRef]
 - Escoubas, P.; Lajide, L.; Mitzutani, J. An improved leaf-disk bioassay and its application for the screening of Hokkaido plants. Entomol. Exp. Appl. 1993, 66, 99–107. [Google Scholar] [CrossRef]
 - González-Coloma, A.; Terrero, D.; Perales, A.; Escoubas, P.; Fraga, B.M. Insect antifeedant ryanodane diterpenes from Persea indica. J. Agric. Food Chem. 1996, 44, 296–300. [Google Scholar] [CrossRef]
 - Song, Z.; Li, X.; Xu, K.; Sun, G.; Yang, L.; Huang, L.; Liu, J.; Yin, P.; Huang, S.; Gao, F.; et al. Design, synthesis and insecticidal activity and mechanism research of chasmanthinine derivatives. Sci. Rep. 2022, 12, 15290. [Google Scholar] [CrossRef]
 - Schneider, C.A.; Rasband, W.S.; Eliceiri, K.W. NIH Image to ImageJ: 25 years of image analysis. Nat. Methods 2012, 9, 671–675. [Google Scholar] [CrossRef]
 - One-Way ANOVA Calculator, Including Tukey HSD. Available online: https://www.socscistatistics.com/tests/chisquare2/default2.aspx (accessed on 13 November 2018).
 - Silva, H.H.; Silva, I.G.; Santos, R.M.; Filho, E.R.; Elias, C.N. Larvicidal activity of tannins isolates of Magonia pubescens St. Hil. (Sapindaceae) against Aedes aegypti (Diptera, Culicidae). Rev. Soc. Bras. Med. Trop. 2004, 37, 396–399. [Google Scholar] [CrossRef]
 - Araujo, F.W.; Lemos, T.L.; Militao, J.S.; Filho, R.B. 2-O-Metilinositol e Proantocianidina de Magonia glabrata. St. Hill. Quim. Nova 1993, 17, 128–136. [Google Scholar]
 - Silva, N.L.; Miranda, F.A.; Conceição, G.M. Triagem Fitoquímica de plantas de Cerrado, da Área de Proteção Ambiental Municipal do Inhamum, Caxias, Maranhão. Sci. Plena 2010, 2, 1–17. [Google Scholar]

| Sample 2 | Choice Feeding  Assay  | Non-Choice Feeding Assay | Antifeedant Category | 
|---|---|---|---|
| EE 3 | 92.14 | 95.16 | strong insect antifeedant | 
| F-H/D 3 | 60.52 | −27.67 | weak insect antifeedant | 
| F-E 3 | −108.09 | 61.10 | appetite suppressor | 
| F-B | −6.69 | 60.71 | appetite suppressor | 
| F-W 3 | −74.57 | 44.73 | inactive | 
| C 4 | 97.95 | 99.04 | strong insect antifeedant | 
Disclaimer/Publisher’s Note: The statements, opinions and data contained in all publications are solely those of the individual author(s) and contributor(s) and not of MDPI and/or the editor(s). MDPI and/or the editor(s) disclaim responsibility for any injury to people or property resulting from any ideas, methods, instructions or products referred to in the content.  | 
© 2023 by the authors. Licensee MDPI, Basel, Switzerland. This article is an open access article distributed under the terms and conditions of the Creative Commons Attribution (CC BY) license (https://creativecommons.org/licenses/by/4.0/).
Share and Cite
Moraes, A.R.A.; Sabina, S.R.; Expósito, D.G.; Giménez, C.; Espinel, G.; Sousa, G.F.; Duarte, L.P.; Jiménez, I.A.; Cabrera, R.; Bazzocchi, I.L. Evaluation of Magonia pubescens A. St.-Hill. Roots Extract against Phytopathogens: Searching for Eco-Friendly Crop Protection Products. Appl. Sci. 2023, 13, 6736. https://doi.org/10.3390/app13116736
Moraes ARA, Sabina SR, Expósito DG, Giménez C, Espinel G, Sousa GF, Duarte LP, Jiménez IA, Cabrera R, Bazzocchi IL. Evaluation of Magonia pubescens A. St.-Hill. Roots Extract against Phytopathogens: Searching for Eco-Friendly Crop Protection Products. Applied Sciences. 2023; 13(11):6736. https://doi.org/10.3390/app13116736
Chicago/Turabian StyleMoraes, Acácio R. A., Samuel R. Sabina, Daniela G. Expósito, Cristina Giménez, Guacimara Espinel, Grasiely F. Sousa, Lucienir P. Duarte, Ignacio A. Jiménez, Raimundo Cabrera, and Isabel L. Bazzocchi. 2023. "Evaluation of Magonia pubescens A. St.-Hill. Roots Extract against Phytopathogens: Searching for Eco-Friendly Crop Protection Products" Applied Sciences 13, no. 11: 6736. https://doi.org/10.3390/app13116736
APA StyleMoraes, A. R. A., Sabina, S. R., Expósito, D. G., Giménez, C., Espinel, G., Sousa, G. F., Duarte, L. P., Jiménez, I. A., Cabrera, R., & Bazzocchi, I. L. (2023). Evaluation of Magonia pubescens A. St.-Hill. Roots Extract against Phytopathogens: Searching for Eco-Friendly Crop Protection Products. Applied Sciences, 13(11), 6736. https://doi.org/10.3390/app13116736
        
